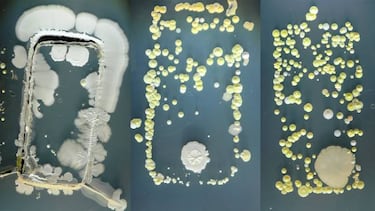
¿Sabías que tu móvil tiene más bacterias que la taza del water?

¿Sabías que tu móvil tiene más bacterias que la taza del water?
No es broma. Varios estudios reseñan que el aparato que más tocamos al día tiene más gérmenes.

Hay cosas que hacemos y damos por sentado que no son malas, y otras que sí. Por ejemplo: ¿a que nunca se os ocurriría ir al baño, tocar la taza del water y luego, sin lavaros las manos, coger un sandwich, un helado, y coméroslo? ¿O llevaros el dedo a la boca por el motivo que sea? Pero, ¿a que no le dais tanta importancia si cambiamos el retrete por el móvil? ¿A que podéis estar usando el móvil y comiendo un sandwich o un helado al mismo tiempo? Pues eso es PEOR y mucho más antihigiénico. ¿Por qué? Pues porque así lo dice la Ciencia y nuestros actos diarios.
Más bacterias que un water
Esta es ideal para los/as aprensivos: ¿Sabíais que esa pantalla que tocáis más de cien veces al día, y esa carcasa que sujetáis incluso en la cama tiene una concentración de bacterias 18 veces mayor que la que se encuentra en un water? Pues sí, porque cada vez que lo tocas le estás transfiriendo los microbios y virus que lleves en las manos tras un día tocando cosas como la barra del metro, el volante del coche, la puerta de la oficina, el interruptor del baño… Además, cuando se habla por él seguimos inspirando y expirando aire, por lo que respiramos todos los microorganismos que se hayan pegado al terminal.
Y es que los móviles entran en contacto con muchísimos elementos, tanto en casa como fuera, y aunque lleven funda, dejarlos sobre una mesa de bar por ejemplo provoca esto mismo y a gran escala. O cogerlos después de haber tocado uno de los objetos más cargados microbiológicamente hablando de toda la casa: el estropajo de fregar de la cocina, básicamente un enorme criadero de cultivo de gérmenes con el que lo lavamos todo a la hora de fregar (pensad en ello: los vasos, los cubiertos…).
En sí, la piel humana está cubierta de microbios que no suelen tener consecuencias negativas para la salud. Pero esas bacterias naturales y el aceite usual de las manos suelen pasar al móvil cada vez que lo tocas. Si analizamos la pantalla de un smartphone, quizás podamos encontrar bacterias como los Estafilococos, pero donde debemos prestar especial atención es al entorno, elementos como los comentados antes, desde el botón del ascensor que cientos de personas van a tocar al día, al pomo de la puerta del baño -el de la parte de dentro, por si alguien no se ha lavado las manos. Estreptococos, MRSA, incluso bacterias fecales como el E.coli pueden campar a sus anchas por la pantalla de tu smartphone.
NUNCA en el baño
¿Alguien de la casa o del trabajo está enfermo? Pues imaginad que estornuda o tose cerca de vuestro teléfono. Esa es otra manera de pasar gérmenes, de hecho podemos pillar un resfriado de esta manera. Pero una de las que ningún experto recomienda es que se use el terminal en el baño, una práctica común para muchos. Ir a hacer nuestras necesidades mientras lo miramos puede provocar que este se contamine con E.coli.

Noticias relacionadas
Pero no os preocupéis, que nadie se pone malo usando el móviligual que no lo hace al tocar el estropajo o limpiarse en una toalla de manos que lleva varios días puesta, sobre todo si mantiene cierta higiene. Vivimos en un mundo de virus diarios, aunque siempre pensad en limpiarlo cada cierto tiempo y ver dónde dejar el móvil, puesto que después lo tocaréis con las manos y luego esas manos ya sabemos dónde van.
No obstante, si sois aprensivos, existen esterilizadores portátiles para smartphones con los que suprimir cualquier tipo de gérmen. como el Phonesoap 2.0, que además de esterilizar el aparato usando rayos ultravioletas que no lo dañan -y que matan el 99,99% de gérmenes según su publicidad-, es también un cargador. 2x1, mata a los bichos y nos carga la batería. Lo que no haya en Amazon...